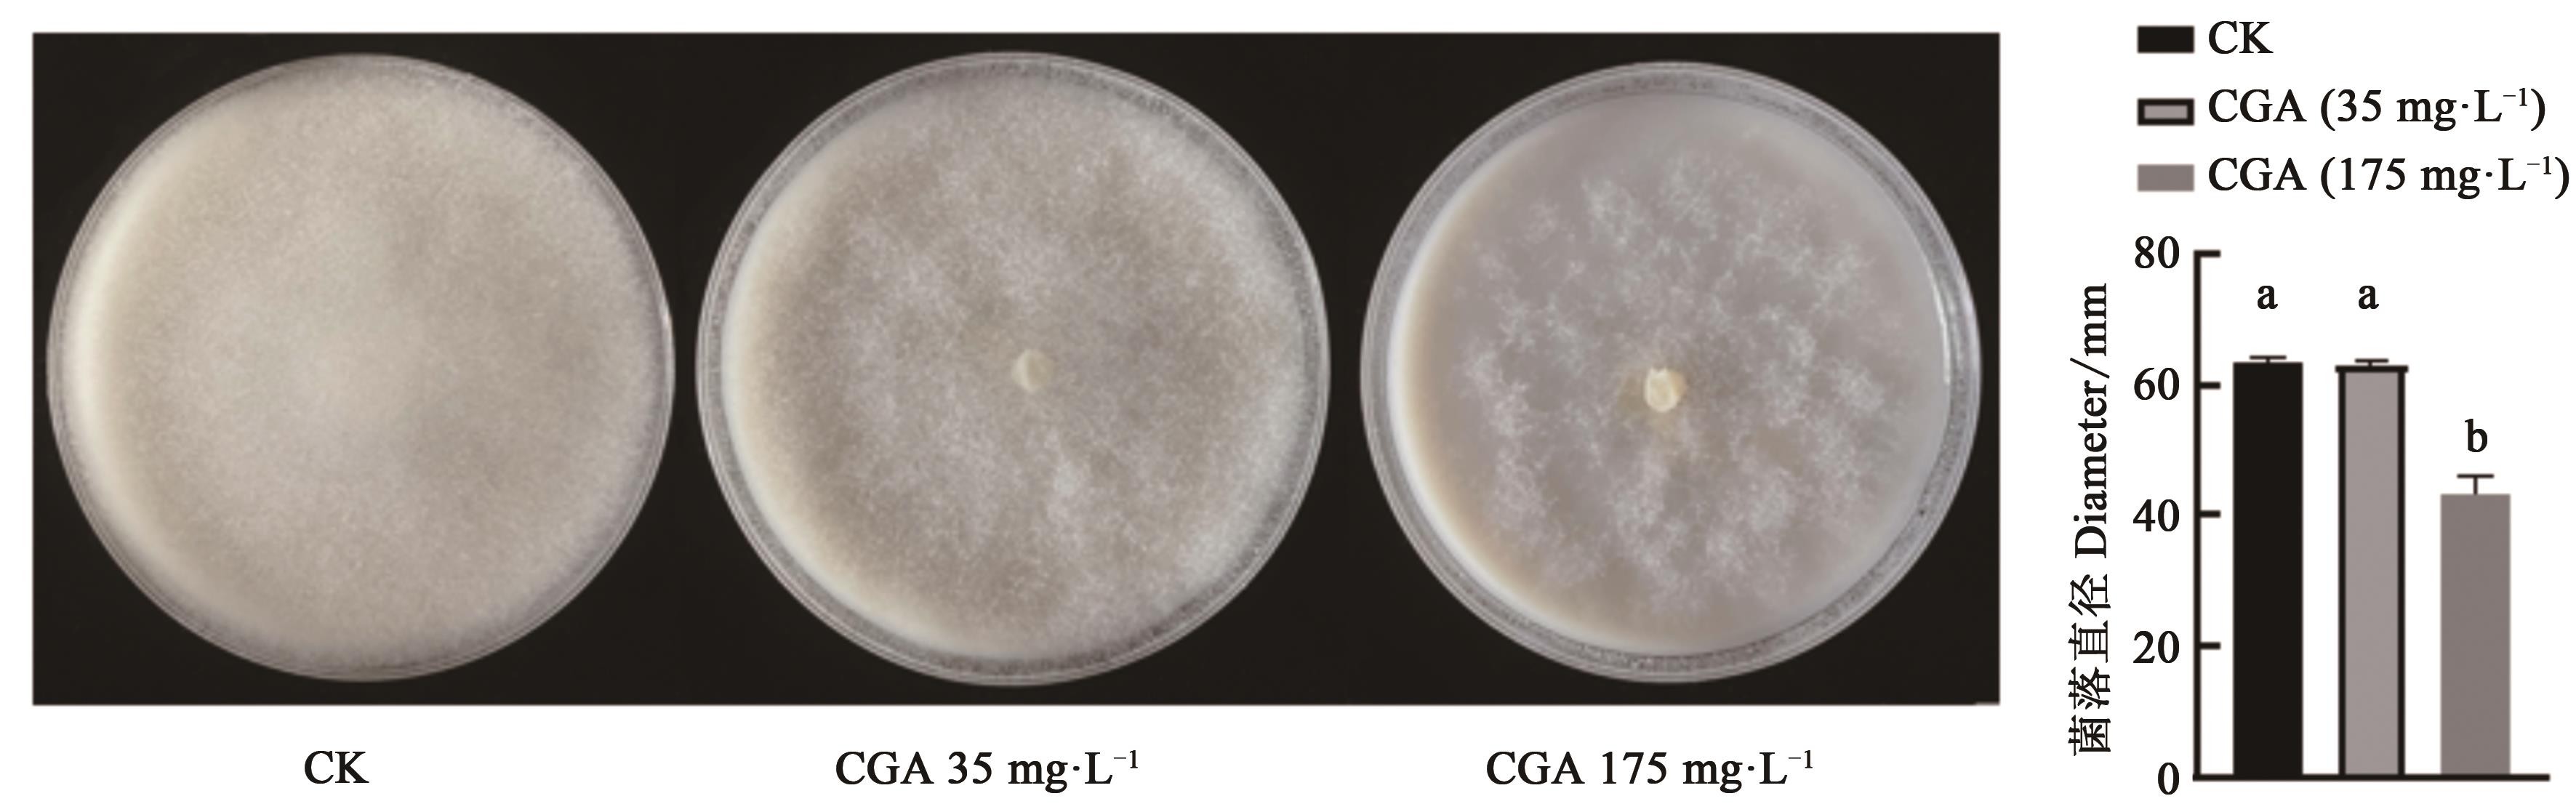

Journal of Agricultural Science and Technology ›› 2023, Vol. 25 ›› Issue (1): 119-127.DOI: 10.13304/j.nykjdb.2021.0888
• ANIMAL AND PLANT HEALTH • Previous Articles Next Articles
Yudan ZHANG1( ), Weimin WANG2, Bo NI3, Xiaohan MA1, Junling LI1, Zicheng XU1, Wei JIA1(
), Weimin WANG2, Bo NI3, Xiaohan MA1, Junling LI1, Zicheng XU1, Wei JIA1( ), Jiuchang SHI2(
), Jiuchang SHI2( )
)
Received:2021-10-18
Accepted:2022-04-12
Online:2023-01-15
Published:2023-04-17
Contact:
Wei JIA,Jiuchang SHI
张豫丹1( ), 王卫民2, 倪博3, 马晓寒1, 李俊领1, 许自成1, 贾玮1(
), 王卫民2, 倪博3, 马晓寒1, 李俊领1, 许自成1, 贾玮1( ), 史久长2(
), 史久长2( )
)
通讯作者:
贾玮,史久长
作者简介:张豫丹E-mail:519086134@qq.com
基金资助:CLC Number:
Yudan ZHANG, Weimin WANG, Bo NI, Xiaohan MA, Junling LI, Zicheng XU, Wei JIA, Jiuchang SHI. Extraction Optimization of Chlorogenic Acid from Tobacco Stalk and Its Antifungal Effect[J]. Journal of Agricultural Science and Technology, 2023, 25(1): 119-127.
张豫丹, 王卫民, 倪博, 马晓寒, 李俊领, 许自成, 贾玮, 史久长. 烟草秸秆绿原酸提取工艺优化及其抑菌效果研究[J]. 中国农业科技导报, 2023, 25(1): 119-127.
Add to citation manager EndNote|Ris|BibTeX
URL: https://nkdb.magtechjournal.com/EN/10.13304/j.nykjdb.2021.0888
| 水平 Level | 因素 Factor | ||
|---|---|---|---|
| A:料液比 Solid-liquid ratio/(g·mL-1) | B:乙醇体积分数 Ethanol volume fraction/% | C:提取温度 Extraction teperature/℃ | |
| -1 | 1∶15 | 50 | 30 |
| 0 | 1∶20 | 60 | 40 |
| 1 | 1∶25 | 70 | 50 |
Table 1 Factors and levels of response surface design
| 水平 Level | 因素 Factor | ||
|---|---|---|---|
| A:料液比 Solid-liquid ratio/(g·mL-1) | B:乙醇体积分数 Ethanol volume fraction/% | C:提取温度 Extraction teperature/℃ | |
| -1 | 1∶15 | 50 | 30 |
| 0 | 1∶20 | 60 | 40 |
| 1 | 1∶25 | 70 | 50 |
编号 No. | 因素 Factor | 绿原酸含量 CGA content/(mg·g-1) | ||
|---|---|---|---|---|
| A | B | C | ||
| 1 | -1 | -1 | 0 | 1.51 |
| 2 | 1 | -1 | 0 | 2.54 |
| 3 | -1 | 1 | 0 | 1.46 |
| 4 | 1 | 1 | 0 | 2.49 |
| 5 | -1 | 0 | -1 | 1.45 |
| 6 | 1 | 0 | -1 | 2.58 |
| 7 | -1 | 0 | 1 | 1.58 |
| 8 | 1 | 0 | 1 | 2.65 |
| 9 | 0 | -1 | -1 | 2.21 |
| 10 | 0 | 1 | -1 | 2.18 |
| 11 | 0 | -1 | 1 | 2.33 |
| 12 | 0 | 1 | 1 | 2.27 |
| 13 | 0 | 0 | 0 | 2.08 |
| 14 | 0 | 0 | 0 | 2.11 |
| 15 | 0 | 0 | 0 | 2.14 |
| 16 | 0 | 0 | 0 | 2.06 |
| 17 | 0 | 0 | 0 | 2.16 |
Table 2 Experimental results of response surface design
编号 No. | 因素 Factor | 绿原酸含量 CGA content/(mg·g-1) | ||
|---|---|---|---|---|
| A | B | C | ||
| 1 | -1 | -1 | 0 | 1.51 |
| 2 | 1 | -1 | 0 | 2.54 |
| 3 | -1 | 1 | 0 | 1.46 |
| 4 | 1 | 1 | 0 | 2.49 |
| 5 | -1 | 0 | -1 | 1.45 |
| 6 | 1 | 0 | -1 | 2.58 |
| 7 | -1 | 0 | 1 | 1.58 |
| 8 | 1 | 0 | 1 | 2.65 |
| 9 | 0 | -1 | -1 | 2.21 |
| 10 | 0 | 1 | -1 | 2.18 |
| 11 | 0 | -1 | 1 | 2.33 |
| 12 | 0 | 1 | 1 | 2.27 |
| 13 | 0 | 0 | 0 | 2.08 |
| 14 | 0 | 0 | 0 | 2.11 |
| 15 | 0 | 0 | 0 | 2.14 |
| 16 | 0 | 0 | 0 | 2.06 |
| 17 | 0 | 0 | 0 | 2.16 |
| 来源 Source | 平方和 Sun of squares | 自由度 DF | 均方 Mean freedom | F值 F value | P值 P value | 显著性 Statistical significance |
|---|---|---|---|---|---|---|
| 模型 Model | 2.42 | 9 | 0.27 | 215.52 | <0.000 1 | *** |
| A | 2.26 | 1 | 2.26 | 1812.80 | <0.000 1 | *** |
| B | 0.004 5 | 1 | 0.004 5 | 3.58 | 0.100 3 | |
| C | 0.02 | 1 | 0.02 | 16.36 | 0.004 9 | ** |
| AB | 0.004 6 | 1 | 0.004 6 | 0.037 | 0.853 8 | |
| AC | 0.001 2 | 1 | 0.001 2 | 0.94 | 0.364 1 | |
| BC | 0.001 7 | 1 | 0.001 6 | 0.14 | 0.724 0 | |
| A2 | 0.092 | 1 | 0.092 | 73.53 | <0.000 1 | *** |
| B2 | 0.005 | 1 | 0.005 | 4.00 | 0.085 6 | |
| C2 | 0.042 | 1 | 0.042 | 33.84 | 0.000 7 | ** |
| 残差 Residuel | 0.008 8 | 7 | 0.001 2 | — | — | |
| 失拟项 Lack of fit | 0.002 2 | 3 | 0.007 2 | 0.44 | 0.736 2 | |
| 纯误差 Pure error | 0.006 6 | 4 | 0.001 6 | — | — | |
| 总差 Cor total | 2.43 | 16 | — | — | — |
Table 3 Variance analysis results of regression model
| 来源 Source | 平方和 Sun of squares | 自由度 DF | 均方 Mean freedom | F值 F value | P值 P value | 显著性 Statistical significance |
|---|---|---|---|---|---|---|
| 模型 Model | 2.42 | 9 | 0.27 | 215.52 | <0.000 1 | *** |
| A | 2.26 | 1 | 2.26 | 1812.80 | <0.000 1 | *** |
| B | 0.004 5 | 1 | 0.004 5 | 3.58 | 0.100 3 | |
| C | 0.02 | 1 | 0.02 | 16.36 | 0.004 9 | ** |
| AB | 0.004 6 | 1 | 0.004 6 | 0.037 | 0.853 8 | |
| AC | 0.001 2 | 1 | 0.001 2 | 0.94 | 0.364 1 | |
| BC | 0.001 7 | 1 | 0.001 6 | 0.14 | 0.724 0 | |
| A2 | 0.092 | 1 | 0.092 | 73.53 | <0.000 1 | *** |
| B2 | 0.005 | 1 | 0.005 | 4.00 | 0.085 6 | |
| C2 | 0.042 | 1 | 0.042 | 33.84 | 0.000 7 | ** |
| 残差 Residuel | 0.008 8 | 7 | 0.001 2 | — | — | |
| 失拟项 Lack of fit | 0.002 2 | 3 | 0.007 2 | 0.44 | 0.736 2 | |
| 纯误差 Pure error | 0.006 6 | 4 | 0.001 6 | — | — | |
| 总差 Cor total | 2.43 | 16 | — | — | — |
编号 No. | 料液比 Material ratio/(g·mL-1) | 提取温度 Extraction temperature/℃ | 乙醇体积分数 Ethanol volume fraction/% | 绿原酸含量 Chlorogenic acid content/(mg·g-1) |
|---|---|---|---|---|
| 1 | 1∶15 | 50 | 50 | 3.51 |
| 2 | 1∶15 | 50 | 50 | 3.47 |
| 3 | 1∶15 | 50 | 50 | 3.50 |
Table 4 Extraction yield of chlorogenic acid in validation experiments
编号 No. | 料液比 Material ratio/(g·mL-1) | 提取温度 Extraction temperature/℃ | 乙醇体积分数 Ethanol volume fraction/% | 绿原酸含量 Chlorogenic acid content/(mg·g-1) |
|---|---|---|---|---|
| 1 | 1∶15 | 50 | 50 | 3.51 |
| 2 | 1∶15 | 50 | 50 | 3.47 |
| 3 | 1∶15 | 50 | 50 | 3.50 |
Fig. 7 Effect of chlorogenic acid on the diameter of P. nicotianaeNote:Different small letters in the figure indicate significant difference at P<0.05 level.
| 1 | 陈栋贤,龚加,杨宇玲,等.烟碱提取及其应用研究进展[J].广州化工, 2021, 49(13): 1-4. |
| CHEN D X, GONG J, YANG Y L, et al.. Research progress of nicotine extraction and its application [J]. Guangzhou Chem. Ind., 2021, 49 (13): 1-4. | |
| 2 | 梁永进,尚海丽,盘文政,等.微生物菌肥对‘K326’烤烟生长发育及产质量的影响[J].中国农学通报,2021, 37(23): 45-51. |
| LIANG Y J, SHANG H L, PAN W Z, et al.. Effects of microbial fertilizer on growth, yield and quality of ‘K326’ flue-cured tobacco [J]. Chin. Agron. Bull., 2021, 37 (23): 45-51. | |
| 3 | 李少明,汤利,范茂攀,等.不同微生物腐熟剂对烟末高温堆肥腐熟进程的影响[J].农业环境科学学报, 2008,27(2): 783-786. |
| LI S M, TANG L, FAN M P, et al.. Effects of different microbial decomposing agents on the decomposition process of tobacco waste high temperature compost [J]. J. Agric. Environ. Sci., 2008,27(2): 783-786. | |
| 4 | LIU Y, DONG J, LIU G, et al.. Co-digestion of tobacco waste with different agricultural biomass feedstocks and the inhibition of tobacco viruses by anaerobic digestion [J]. Bioresour. Technol., 2015, 189: 210-216. |
| 5 | 郑坚强,刘彬,王小飞,等.烟草秸秆纳米纤维素的制备及表征分析[J].河南农业科学, 2021, 50(3): 165-173. |
| ZHENG J Q, LIU B, WANG X F, et al.. Preparation and characterization of tobacco straw nano cellulose [J]. Henan Agric. Sci., 2021, 50 (3): 165-173. | |
| 6 | 赵德清,戴亚,冯广林,等.烟秆的化学成分、纤维形态与生物结构[J].烟草科技, 2016, 49(4): 80-86. |
| ZHAO D Q, DAI Y, FENG G L, et al.. Chemical composition, fiber morphology and biological structure of tobacco stalk [J]. Tob. Sci. Technol., 2016, 49 (4): 80-86. | |
| 7 | 薄国栋,申国明,陈旭,等.秸秆还田对植烟土壤酶活性及细菌群落多样性的影响[J].中国烟草科学, 2017, 38(1): 53-58. |
| BO G D, SHEN G M, CHEN X, et al.. Effects of straw returning on enzyme activity and bacterial community diversity in tobacco planting soil [J]. China Tob. Sci., 2017, 38 (1): 53-58. | |
| 8 | 陈娅,王安琪,刘聪,等.灰毡毛忍冬LmC3H1基因的克隆及表达模式与绿原酸含量相关性分析[J]. 中国实验方剂学杂志, 2020, 26(9): 167-175. |
| CHEN Y, WANG A Q, LIU C, et al.. Cloning and expression pattern of lmc3h1 gene of Lonicera macranthoides and its correlation with chlorogenic acid content [J]. Chin. J. Exp. Prescriptions, 2020, 26 (9): 167-175. | |
| 9 | 马红梅,朱芸菲,魏军,等.藏蒲公英多糖纳米乳对小鼠免疫机能的影响[J].江苏农业科学, 2013, 41(1): 214-216. |
| MA H M, ZHU Y F, WEI J, et al.. Effect of Tibetan dandelion polysaccharide nano emulsion on immune function of mice [J]. Jiangsu Agric. Sci., 2013, 41 (1): 214-216. | |
| 10 | 隋洪玉,李秀霞,赵永勋,等.蒲公英总黄酮提取液对D-gal衰老模型小鼠脑组织的抗氧化作用[J].黑龙江医药科学, 2004(6): 3-4. |
| SUI H Y, LI X X, ZHAO Y X, et al.. Antioxidant effect of total flavonoids extract of dandelion on brain tissue of D-gal aging model mice [J]. Heilongjiang Med. Sci., 2004 (6): 3-4. | |
| 11 | 李月影,王月囡,成娜娜,等.蒲公英燕麦牛奶复合保健饮料制作工艺的研究[J].农产品加工, 2018, 45(4): 38-41. |
| LI Y Y, WANG Y N, CHENG N N, et al.. Study on the preparation technology of dandelion oat milk compound health beverage [J]. Agric. Products Process., 2018, 45 (4): 38-41. | |
| 12 | KAI K, WANG R, BI W, et al.. Chlorogenic acid induces ROS-dependent apoptosis in Fusarium fujikuroi and decreases the postharvest rot of cherry tomato [J]. World J. Microbiol. Biotechnol., 2021, 37(6): 1-9. |
| 13 | MARTINEZ G, REGENTE M, JACOBI S, et al.. Chlorogenic acid is a fungicide active against Phytopathogenic fungi [J]. Pesticide Biochem. Physiol., 2017, 140: 30-35. |
| 14 | 张花,顾丽莉,黄智华,等.烟草多酚的提取分离及分析研究进展[J].化学通报, 2021, 84(9): 900-905. |
| ZHANG H, GU L L, HUANG Z H, et al.. Research progress on extraction, separation and analysis of tobacco polyphenols [J]. Chem. Bull., 2021, 84 (9): 900-905. | |
| 15 | 倪美仙.粮食真菌检验及无菌操作控制方法的探讨[J].粮食与饲料工业, 2014(4): 65-67. |
| NI M X. Discussion on inspection and aseptic operation control methods of grain fungi [J]. Grain Feed Ind., 2014 (4): 65-67. | |
| 16 | 赵御锜,于方园.金银花中绿原酸提取的研究前景和应用概述[J].食品安全导刊, 2019(6): 162. |
| 17 | TROGU L C, MACRAE R. A study of the effect of roasting on the chlorogenic acid composition of coffee using HPLC [J]. Food Chem., 1984, 15(3): 219-227. |
| 18 | 郭华,刁全平,张博,等.杨树口蘑多糖的超声波辅助提取工艺及其抗氧化活性[J].食品工业科技, 2018, 39(5): 180-184. |
| GUO H, DIAO Q P, ZHANG B, et al.. Optimization of ultrasonic-assisted extraction technology and antioxidant activity of Polysaccharide from Tricholoma populinum [J]. Food Ind. Sci. Technol., 2018, 39 (5): 180-184. | |
| 19 | 李爱民,姚元枝,郭瑛,等.超声波提取接骨草叶中绿原酸的工艺优化[J].食品工业科技,2013, 34(17): 232-235, 240. |
| LI A M, YAO Y Z, GUO Y, et al.. Optimization of ultrasonic-assisted extraction process of chlorogenic acid from Sambucus chinensis Lindl.leaves [J]. Food Ind. Sci. Technol., 2013, 34 (17): 232-235, 240. | |
| 20 | TIAN J, BAN X, ZENG H, et al.. The mechanism of antifungal action of essential oil from dill (Anethum graveolens L.) on Aspergillus flavus [J/OL]. PLoS One, 2012, 7(1): e30147 [2022-09-02]. . |
| 21 | 沈奇,金春雁,张卫明,等.蒲公英绿原酸及其包合物对葡萄保鲜作用的研究[J].食品科学, 2007, 28(6): 332-335. |
| SHEN Q, JIN C Y, ZHANG W M, et al.. Effects of dandelion chlorogenic acid and its inclusion compounds on grape preservation [J]. Food Sci., 2007, 28(6): 332-335. | |
| 22 | 何念武,杨超.杜仲叶绿原酸对果蔬保鲜作用的试验研究[J].江西农业学报, 2018, 30(11): 71-75. |
| HE N W, YANG C. Experimental study on preservation of fruits and vegetables by chlorogenic acid from Eucommia ulmoides leaves [J]. Jiangxi Agric. J., 2018, 30 (11): 71-75. | |
| 23 | JIAO W, LI X, WANG X, et al.. Chlorogenic acid induces resistance against Penicillium expansum in peach fruit by activating the salicylic acid signaling pathway [J]. Food Chem., 2018, 260(15): 274-282. |
| 24 | XUE L J, GUO W, YUAN Y, et al.. Constitutively elevated salicylic acid levels alter photosynthesis and oxidative state but not growth in transgenic Populus [J]. Plant Cell, 2013, 25(7): 2714-2730. |
| 25 | 凌天孝,陈健,薛延丰,等.肉桂醛对烟草疫霉菌的体外抑制作用[J].中国烟草学报, 2017, 23(4): 70-76. |
| LING T X, CHEN J, XUE Y F, et al.. Inhibitory effect of cinnamaldehyde against Phytophthora nicotiance in vitro [J]. Acta Tabacaria Sin., 2017, 23 (4): 70-76. |
| [1] | Chongtao LIU, Tong LI, Yangyang LI, Zhuangzhuang LIU, Yangyang CAI, Jianchao SONG, Wantong ZHANG, Bin SHANG, Xiuping TAO. Study on Antifungal Effect and Composition of Ultraviolet on Nutritional Wastewater [J]. Journal of Agricultural Science and Technology, 2024, 26(7): 166-173. |
| [2] | Fenfang XIAO, Conghe ZHANG, Hui WANG, Yafeng YE, Daolin ZHANG, Heting WANG, Bo LI, Yuejin WU, Binmei LIU. Simulation and Optimization of Pneumatic Conveying System for Hybrid Rice Pollen Collection Device [J]. Journal of Agricultural Science and Technology, 2023, 25(4): 110-122. |
| [3] | Dingyang ZHANG, Saifei QIU, Wenhua RAO, Xueping GUO, Fang CAO, Tianyun ZHAI, Xiong GUAN, Xiaohong PAN. Inhibitory Effect of Nano-Mg(OH)2 with Different Morphology on Pathogen Mango Phoma Leaf Spot [J]. Journal of Agricultural Science and Technology, 2022, 24(3): 140-147. |
| [4] | HU Ruirui1,2, SHEN Guoming1*, GAO Lin1, ZHANG Xiaoming3, XIA Shuqin3, CHENG Changhe4, LI Liqun5, WANG Yingqi6, WANG Shujian6. Preparation of Tobacco Chlorogenic Acid Nanoliposome and Its Stability Analysis [J]. Journal of Agricultural Science and Technology, 2017, 19(4): 128-137. |
| [5] | DING Ren-fang, FENG Su, XIE Chen-wen, ZHANG Xing-li, LIU Xiao-xue, ZHANG Jie*. The new Fermentation Method to Produce Chlorogenic Acid by a Strain of Bacillus subtilis with Ipomoea batatas Leaves [J]. Journal of Agricultural Science and Technology, 2016, 18(4): 181-189. |
| [6] | WANG Xue-bing, CUI Bao-an, WEI Zhan-yong, QIU Jin-li, XU Duan-hong. Studies on Antiviral Effect of |Chlorogenic Acid on PRRSV in vitro [J]. , 2008, 10(3): 107-110. |
| Viewed | ||||||
|
Full text |
|
|||||
|
Abstract |
|
|||||
 京公网安备11010802021197号
京公网安备11010802021197号